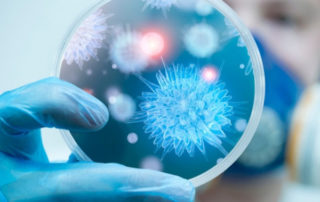
Controlo da infeção no consultório dentário

3001, 2020
Implante Dentário Unitário
Implante Dentário Unitário Se perdeu um dente recentemente ou tem próteses totais [...]
3001, 2020
Implantes Dentários Múltiplos
Implantes Dentários Múltiplos Se perdeu mais de um dente recentemente ou tem próteses [...]
3001, 2020
Isolamento do Campo Operatório
Isolamento do Campo Operatório Vantagens do uso do isolamento do campo operatório [...]
3001, 2020
Controlo da Infeção no Consultório Dentário
Controlo da Infeção no Consultório Dentário Cuidados que se têm no consultório [...]
2801, 2020
Síndrome de dente Fissurado e Fratura Vertical da Raiz
Síndrome de dente Fissurado e Fratura Vertical da Raiz Existem muitos diferentes [...]
2801, 2020
Endodontia – O que é?
Endodontia – O que é? Quando estes tecidos ou os que rodeiam o [...]